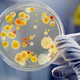

-
0 A 50 DC....
Los asiáticos , babilónicos mas exactamente los egipcios utilizaban microorganismos para la elaboración de bebidas alcohólicas y en la fabricación del pan y de diferentes alimentos. -
Dice que los germenes vivos pasan de un individuo a otro
-
Giloramo Fracastoro escribió dos libros para la medicina , el primero trataba sobre la aparición de la sífilis en Europa , el otro libro trata sobre el contagio de enfermedades en el cual Fracastoro sugiere que organismos tan pequeños casi invisibles son los causantes de las diferentes enfermedades.
-
FRANCISCO REDI era un medico italiano , descubrió que las moscas no se originaban por generación espontánea sino por nacimiento de larvas .Por esta razon se considera el padre de la helmintología.Teniendo en cuenta que los huevos de moscas son muy pequeños se considera de avance en la microbiología.
-
Rober Hooke en la microbiología fue el primer científico que observo detalladamente y realizó la descripcion de hongos.Además fue aquel que describió y utilizó por primera vez el significado de célula estableciendola como unidad fundamental de todo ser vivo.
-
ANTON VAN LEEUWENHOEK REALIZO LA PRIMERA DESCRIPCION PRECISA DE LOS GLOBULOS ROJOS DE LA SANGRE
-
ANTON VAN LEEUWENHOEK REALIZO LA PRIMERA DESCRIPCION DE LOS GLOBULOS ROJOS,OBSERVANDOLOS EN EL AGUA.
-
ANTON VAN LEEUWENHOEK OBSERVO EN EL AGUA DE UN ESTANQUE, EN EL AGUA DE LLUVIA Y EN LA SALIVA HUMANA , LO QUE EL LLAMARIA ANIMÀLCULOS CONOCIDOS EN LA ACTUALIDAD COMO PROTOZOOS Y BACTERIAS.
-
Se dedicó a pulir lentes y a observar todos los tejidos que iba construyendo. Estudió granos de polen, fluidos corporales, sarro de los dientes, y vio unas pequeñas estructuras que podían moverse y las llamó animáculos.
-
ANTON VAN LEEUWENHOEK DESCRIBIO LOS ESPERMATOZOOS DE LOS INSECTOS Y LOS SERES HUMANOS
-
Prolongando el periodo de calentamiento y sellando con más cuidado losrecipientes, Spallanzani pudo demostrar que dichos caldos no generabanmicroorganismos mientras los recipientes estuvieran sellados.
-
Edwar Jenner demostro que la inoculacion de material procedente de la viruela vacuna (virus de la vacuna o "Cowpox" proporciona inmunidad a los seres humanos contra la viruela).
-
Franz Schulze es un zoologo y anatomista alemán .Realizo un experimento que trataba básicamente de el paso del aire sobre un caldo con soluciones acidas fuertes que en su interior tenia carne hervida obteniendo como resultados la inexistencia de vida refutando la generación espontánea.
-
Anatomista prusiano considerado uno de los fundadores de la teoría celular, descubrió el musculo estriado ,describió la vaina de Schwann, confirmo el experimento de Schulze pero el lo realizo básicamente pasando aire sobre tubos calientes confirmando así la inexistencia de seres vivos esporádicamente.
-
Joseph-Henri Léveilléb fue un medico y micólogo francés y es el primero en dar una descripción completa en su obra sobre la estructura de los hongos bacidiomiceto
-
Semmelweis, establece la etiología de las fiebres puerperales
-
Lister, introduce la asepsia quirúrgica, pulverización fenol en las salas donde se intervenía quirúrgicamente.
-
Médico rural alemán que observó la presencia de microorganismos en la sangre de animales. Fue el primero que desarrolló o que aisló un microorganismo en cultivo puro. Postulados de Koch: Un microorganismo es el responsable de una enfermedad o de otro proceso cualquiera.
Postulado 1: El microorganismo debe estar presente en animales afectados y ausente en los sanos.
Postulado 2: El microorganismo debe ser aislado en un medio de cultivo puro.
Postulados 3 y 4: Este microorganismo que hemos -
PASTEUR DESCUBRIÒ QUE PODIA UTILIZARSE VACTERIAS AVIRULENTAS COMO VACUNA CONTRA EL CÒLERA AVIARIO: EL ACUÑO LA PALABRA VACUNA.
-
Bomm del cual no aparece información fue el primero en lograr un cultivo con gonococo (responsable de la gonorrea) y estudiar el comportamiento de esos microorganismos.
-
Richard Petri era un bacteriólogo alemán al cual se le atribuye la invención de las placas de petri , mientras era asistente de Koch , estas placas han sido de gran importancia para la microbiología ya que sirve para albergar los cultivos bacteriológicos.
-
chaudinn junto a hoffman descubren la espiroqueta causante de producir la sífilis.Shaudinn era filosofo alemán y fallece muy joven aproximadamente a los 35 años de edad a causa de una infección amebiana.
-
Paul Ehrlich fue un médico bacteriólogo alemán ganador del premio nobel de medicina en 1908 , descubrió los anticuerpos y la barrera hematoencefálica, realizó grandes aportes a la quimioterapia ya que descubrió las llamadas balas mágicas que sirvieron de cura para muchas enfermedades.
-
Paul Ehrilch introdujo una sustancia quimica con arsenico demoninada salvarsan para el tratamiento de la sifilis
-
ALEXANDER FLEMING DESCUBRIÒ EL ANTIBIOTICO PENICILINA
-
SE OBSERVARON POR PRIMERA VEZ LOS VIRUS GRACIAS A LA INVENCION DEL MICROSCOPIO ELECTRONICO
-
Alfred Hershey y Martha Chase demuestran que el DNA era el material genético de algunos virus.
-
Heinz Ludwig Fraenkel-Conrat y Robley Williams demuestran que el RNA era el material genético del virus del mosaico del tabaco.
-
SE DESCUBRIERON NUMEROSOS VIRUS Y SE DETERMINARON SUS CARACTERISTICAS FISICAS Y QUIMICAS.
-
WHITTAKER DISTRIBUYÒ A LOS SERES VIVOS EN CINCO REINOS:
MONERAS
PROTISTAS
HONGOS
PLANTAS
ANIMALES -
CARL WOESE CONSTRUYE UN ARBOL FILOGENETICO APARTIR DE LOS ESTUDIOS DEL ARNr; DE ESTE TRONCO SURGIERON LA EVOLUCION DE TRES MODELOS DE CELULAS Y UNA CLASIFICACION EN 3 DOMINIOS
BACTERIA
ARCHAE
EUCARYA -
Las bacterias pueden tener cromosomas lineales.
-
Luc Montagnier esnun virólogo francés importante por descubrir el virus de inmunodeficiencia humana (VIH) y su estructura.Por el cual recibió en el año 2008 el premio nobel de medicina.
-
En México aparece un brote de gripe porcina, posteriormente llamada gripe A H1N1
-
Se descubre el proceso de esporulación en Mycobacterium.
-
Prusiner descubre los priones, agentes causantes de la encefalopatía espongiforme bovina y de la enfermedad de Creutzfeldt-Jakob.
Want to make a timeline like this?
Use Timetoast to turn dates, events, milestones, and phases into a clear visual timeline you can build and share. Timetoast is a timeline maker for work, school, research, and stories.